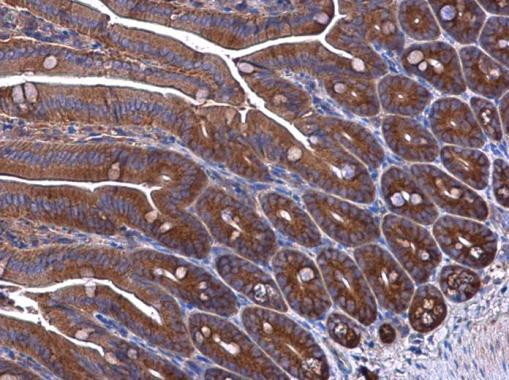
EPRS Antibody in Immunohistochemistry (Paraffin) (IHC (P))

Search
Invitrogen
EPRS Polyclonal Antibody
{{$productOrderCtrl.translations['antibody.pdp.commerceCard.promotion.promotions']}}
{{$productOrderCtrl.translations['antibody.pdp.commerceCard.promotion.viewpromo']}}
{{$productOrderCtrl.translations['antibody.pdp.commerceCard.promotion.promocode']}}: {{promo.promoCode}} {{promo.promoTitle}} {{promo.promoDescription}}. {{$productOrderCtrl.translations['antibody.pdp.commerceCard.promotion.learnmore']}}
图: 1 / 4
EPRS Antibody (PA5-77966) in IHC (P)




产品信息
PA5-77966
种属反应
宿主/亚型
分类
类型
抗原
偶联物
形式
浓度
规格
纯化类型
保存液
内含物
保存条件
运输条件
RRID
产品详细信息
Positive Control: 293T, A431, HeLa, HepG2
Predicted Reactivity: Chicken (84%), Bovine (90%)
Store product as a concentrated solution. Centrifuge briefly prior to opening the vial.
靶标信息
Aminoacyl-tRNA synthetases are a class of enzymes that charge tRNAs with their cognate amino acids. EPRS is a multifunctional aminoacyl-tRNA synthetase that catalyzes the aminoacylation of glutamic acid and proline tRNA species.
仅用于科研。不用于诊断过程。未经明确授权不得转售。
篇参考文献 (0)
生物信息学
蛋白别名: Bifunctional aminoacyl-tRNA synthetase; Bifunctional glutamate/proline--tRNA ligase; Cell proliferation-inducing gene 32 protein; glutamate tRNA ligase; Glutamatyl-prolyl-tRNA synthetase; glutamine-proline-tRNA synthetase; glutaminyl-tRNA synthetase; N-terminal fragment of glutamyl-prolyl tRNA synthetase covering ERS domain and two upstream WHEP domains; proliferation-inducing gene 32 protein; proliferation-inducing protein 32; proline-tRNA ligase; prolyl-tRNA synthetase; unnamed protein product
基因别名: 2410081F06Rik; 3010002K18Rik; C79379; EARS; EPRS; EPRS1; GLNS; GLUPRORS; HLD15; PARS; PIG32; QARS; QPRS
UniProt ID: (Human) P07814, (Mouse) Q8CGC7
Entrez Gene ID: (Human) 2058, (Mouse) 107508